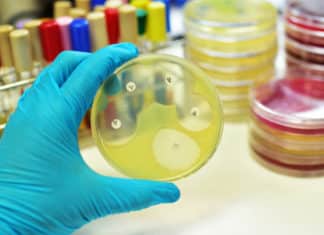
Researchers Develop Synthetic Polymer Capable of Vanquishing Superbugs

Scientists Develop Bio-Sunblock Using Engineered Bacteria
Scientists Develop Bio-Sunblock Using Engineered Bacteria
The science on sun exposure is clear: too much of the sun’s ultraviolet radiation leads to sunburns, rapidly aging skin, and...
Apple to Launch Medical Clinic for Employees
Apple to Launch Medical Clinic for Employees
Close on the heels of Amazon’s surprising turn into the healthcare industry through Warren Buffet's Berkshire Hathaway, tech...
CSBMM, Yenepoya Research Centre Workshops on Genomics, Proteomics and Metabolomics
CSBMM, Yenepoya Research Centre Workshops on Genomics, Proteomics and Metabolomics.
Title: Centre for Systems Biology and Molecular Medicine at Yenepoya Research Centre announces upcoming series...
Biotecnika Times – Newsletter 09.03.2018 – Tata Innovation Fellowship 2018
Biotecnika Times - Tata Innovation Fellowship 2018
Tata Innovation Fellowship 2017-18 For Life Sciences & Biotech
Official notification for Tata Innovation Fellowship 2017-18 is given below. DBT...
In a First, Scientists Genetically Engineer Crop to Take Up 25%...
In a First, Scientists Genetically Engineer Crop to Take Up 25% Less Water
Demand for primary foodstuffs, that is, grains and seeds of our major...
Reformed Cancer Vaccine Raises Biomaterial-Strategy’s Clinical Potential
Reformed Cancer Vaccine Raises Biomaterial-Strategy’s Clinical Potential
One of the reasons cancer is so deadly is that it can evade attack from the body’s immune...
Antibiotics Use and Its Influence on Cancer Treatment
Antibiotics Use and Its Influence on Cancer Treatment
In recent years the combined use of chemotherapy and immunotherapy, collectively termed chemoimmunotherapy, has emerged as a...
Antiretroviral Treatment Aimed at Primates Targets, Suppresses Viral Reservoir
Antiretroviral Treatment Aimed at Primates Targets, Suppresses Viral Reservoir
HIV therapies have improved to the point that combinations of antiretroviral (ARV) drugs routinely knock down...
3D Printed Patches that Produce Tissue-Saving Vascular Networks
3D Printed Patches that Produce Tissue-Saving Vascular Networks
Arterial bypass grafts remain the gold standard for the treatment of end-stage ischaemic disease. Yet patients unable...
Impaired “Epigenetic Landscape” Hallmark of Alzheimer’s : Study
Impaired “Epigenetic Landscape” Hallmark of Alzheimer’s : Study
Alzheimer’s Disease (AD) is the most common cause of dementia in the elderly. A complex interaction between...
Project Assistantship Position Vacant @ GBPUAT
Project Assistantship Position Vacant @ GBPUAT
Apply for Biosciences jobs at GBPUAT. GBPUAT hiring for Project Associate position is vacant at GBPUAT. Check details on the...
National Women Bioscientist Awards 2017-2018
National Women Bioscientist Awards 2017-2018
Apply for the DBT India National Women Bioscientist Awards 2017-2018. Notification is out for DBT National Women Bioscientist Awards 2017-2018. Check the...
Tata Innovation Fellowship 2017-18 For Life Sciences & Biotech
Tata Innovation Fellowship 2017-18 For Life Sciences & Biotech
Check the details on Tata Innovation Fellowship 2018. Official notification for Tata Innovation Fellowship 2017-18 is given...
Biotecnika Times – Newsletter 08.03.2018 – INSA Hiring Life Science Candidates
Biotecnika Times - INSA Hiring Life Science Candidates, Biocon Research
Life Sciences Job @ Indian National Science Academy With Rs. 40,000 pm Salary
Apply for Programme Associate...
Researchers Develop Synthetic Polymer Capable of Vanquishing Superbugs
Researchers Develop Synthetic Polymer Capable of Killing Superbugs
With no effective and safe treatments available, multidrug-resistant (MDR) infections are quickly morphing into a global healthcare...
Cell Cycle Regulation to Enable Cardiac Regeneration
Cell Cycle Regulation to Enable Cardiac Regeneration
Through normal wear and tear, our tissues experience regular cell loss that is countered by replenishment mechanisms. Aging...
Novel Biological Sample Storage Method Not Requiring Refrigeration Developed
Novel Biological Sample Storage Method Not Requiring Refrigeration Developed
Handling, transport, and storage of biospecimens such as blood and urine without refrigeration are extremely challenging....
Common Superbug Found to Exhibit “Heteroresistance” to Last-Resort Antibiotic
Common Superbug Found to Exhibit “Heteroresistance” to Last-Resort Ab
In a concerning find, scientists have now detected “heteroresistance” in the already highly resistant Klebsiella pneumoniae, a...
Geneticists Build World’s Biggest Family Tree Involving 13 Million People Across...
Geneticists Build World’s Biggest Family Tree Involving 13 Million People Across 11 Generations
Family trees are mathematical graph structures that can capture mating and parenthood...
23andMe’s Direct-To-Consumer Genetic Cancer Risk Test Receives FDA Nod
23andMe's Direct-To-Consumer Genetic Cancer Risk Test - FDA Approved
The first direct-to-consumer DNA test for three BRCA1/BRCA2 breast cancer gene mutations has now received the federal...